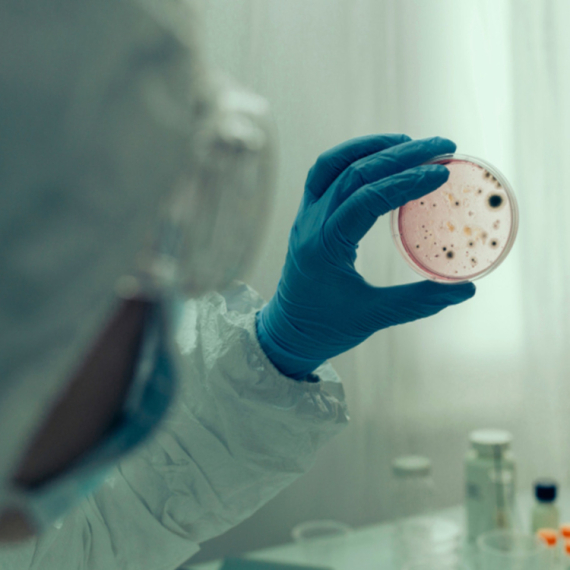
Izbila epidemija kolere: Umrlo 58 ljudi

Horor u Nigeriji: Više od sedam hiljada ljudi zaraženo kolerom
U epidemiji kolere koja je izbila početkom maja na severoistoku Nigerije preminulo je najmanje 74 osoba, a zaraženo je više od 7.800 ljudi, saopštila je danas organizacija Lekari bez granica.
18:50
9.6.2026.
25 d